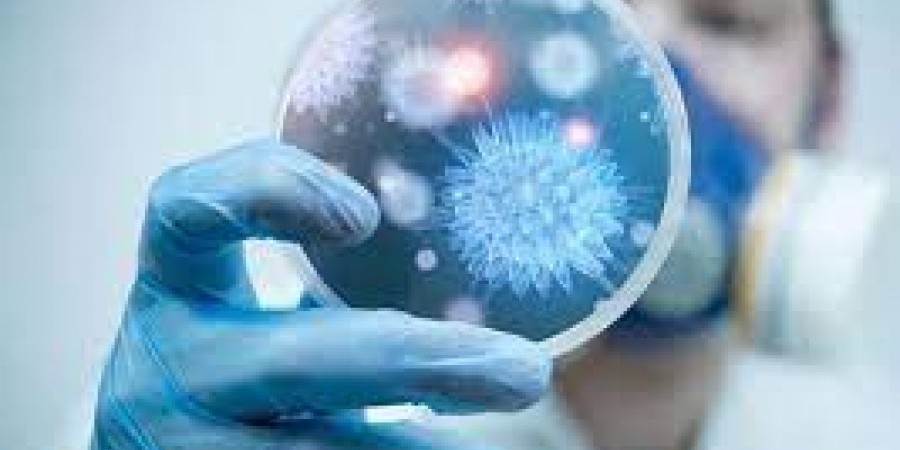
d7b952b94f2cc80c303dbab25847bbcb

Η γεωγραφική κατανομή των κρουσμάτων από rapid τεστ (ΠΙΝΑΚΑΣ)
Το Υπουργείο Υγείας ανακοίνωσε την Κυριακή (5/9) δύο νεκρούς και 147 νέα κρούσματα κορωνοϊού στην Κύπρο. Από τις 29,833 διαγνώσεις που διενεργήθηκαν σήμερα οι 4,994 έγιναν με τη μοριακή μέθοδο (PCR) και οι 24,839 με τη μέθοδο ταχείας ανίχνευσης αντιγόνου (antigen rapid test), εντοπίστηκαν 147 περιστατικά της νόσου COVID-19, που προέκυψαν ως εξής: 7 […]